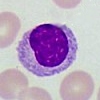
Monocytes

Red blood cell

|
cytoplasm = orange-pink to rose
|
Neutrophil

|
granules = purple-to-lilac small granules
cytoplasm = pale pink
nucleus = dark purple
|
Eosinophil

|
granules = orange to pink large granules
cytoplasm = pale pink
nucleus = blue
|
Basophil

|
granules = deep blue almost black large granules
nucleus = purple to dark blue
|
Lymphocyte

|
cytoplasm = sky blue cytoplasm
nucleus = dark purple to deep bluish purple
|
Monocyte
|
cytoplasm = pale gray-blue
nucleus = deep bluish-purple
|
Platelets

|
central granules = red-purple surrounded by light blue
|
